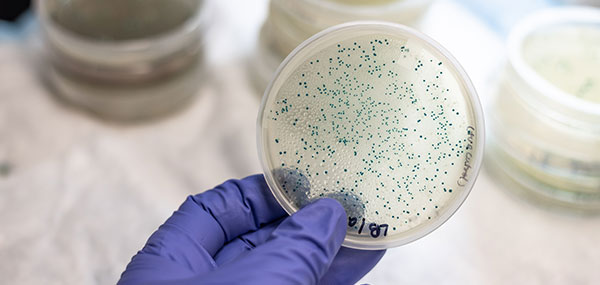
Header3

Welcome to Premium United Care, LLC
Premium United Care, LLC specializes in caring for patients with infectious diseases by providing infectious consultation services in hospital and in the office setting. Conditions we specialize in treating include HIV/AIDS, MRSA, and soft tissue infections.